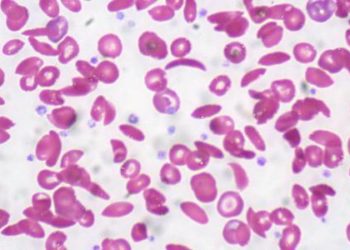
Stem cell transplant may be effective in sickle cell disease

Sickle cell trait associated with preexisting kidney comorbidities and increased COVID-19 mortality
1. Sickle cell trait was associated with increased COVID-19 mortality and various preexisting chronic medical conditions, particularly in persons of ...